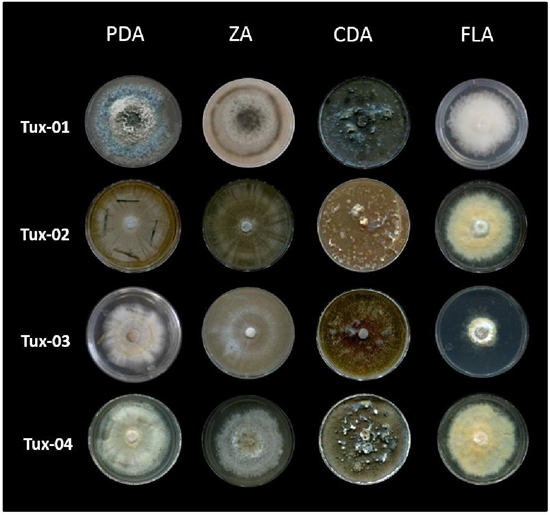

Services on Demand
Journal
Article
Indicators
-
 Cited by SciELO
Cited by SciELO -
 Access statistics
Access statistics
Related links
-
 Similars in
SciELO
Similars in
SciELO
Share
Revista mexicana de ciencias agrícolas
Print version ISSN 2007-0934
Rev. Mex. Cienc. Agríc vol.10 spe 23 Texcoco Sep./Nov. 2019 Epub Nov 20, 2020
https://doi.org/10.29312/remexca.v0i23.2027
Articles
New causes of rot in rubber sting panel: case Fusarium spp.
1Universidad Michoacana de San Nicolás de Hidalgo-Facultad de Agrobiología ‘Presidente Juárez’. Paseo Lázaro Cárdenas esquina con Berlín, Uruapan, Michoacán, México. CP. 60040. (bernardolopez@tmtagro.com.mx; gutierrezcon.maribel@gmail.com; aguirrepaleo@hotmail.com; atahualpagc@hotmail.com; garsapan@gmail.com).
2Facultad de Biología-Universidad Michoacana de San Nicolás de Hidalgo. Avenida Francisco J. Múgica s/n, Ciudad Universitaria, Edificio B-1, Morelia, Michoacán, México. CP 58060. (vargasmarga@hotmail.com).
Moldy rot on the rubber sting panel decreases the yield and regeneration of its bark. The objective was to identify the causative agent of the disease in San Juan Bautista Tuxtepec, Oaxaca and evaluate its in vitro sensitivity to fungicides. To this end, tissue from the diseased sting panel was collected and made insulations. The isolates were characterized in the nutritive media PDA (papa-dextrose-agar), CLA (carnation leaves-agar), FLA (liquid fermentation-agar), CDA (coffee-dextrose-agar) and ZA (carrot-agar). Growth rates were evaluated and pathogenicity tests were carried out in the laboratory and in the field, as well as in vitro sensitivity to Mancozeb 70%, Benomilo, Carbendazin, Propiconazole, Chlorothalonil, and Carboxamide, in 10 treatments and eight repetitions. The results showed four isolates of the genus Fusarium, which showed polymorphism according to the culture medium, with radial growth and marked rings. Microconidia and macroconidia dispersed in the mycelium and white, orange and blue sporodochs were observed at 36 days. The growth rate varied with the nutrient medium and the inoculated strain. F. circinatum, F. lateririum, F. decemcellulare and F. mangiferae were identified. In the laboratory pathogenicity tests all inoculated strains were positive and in the field only F. circinatum and F. mangiferae. The sensitivity bioassay showed fungicide-dependent response and isolation. These results allow us to conclude that the species F. circinatum, F. mangiferae, F. lateririum and F. decemcellulare can cause moldy rot in the sting panel of clone IAN 710. This is a first report that involves these species. Its control depends on the species of Fusarium and the fungicide used.
Keywords: characterization; culture media; fungicide sensitivity; identification
La pudrición mohosa en el panel de pica de hule disminuye el rendimiento y la regeneración de su corteza. El objetivo fue identificar el agente causal de la enfermedad en San Juan Bautista Tuxtepec, Oaxaca y evaluar su sensibilidad in vitro a fungicidas. Para ello se colectó tejido del panel de pica enfermo y realizaron aislamientos. Se caracterizaron los aislados en los medios nutritivos PDA (papa-dextrosa-agar), CLA (hojas de clavel-agar), FLA (fermentación líquida-agar), CDA (café-dextrosa-agar) y ZA (zanahoria-agar). Se evaluaron tasas de crecimiento y realizaron pruebas de patogenicidad en laboratorio y campo, así como de sensibilidad in vitro a Mancozeb 70%, Benomilo, Carbendazin, Propiconazol, Clorotalonil, y Carboxamida, en 10 tratamientos y ocho repeticiones. Los resultados evidenciaron cuatro aislados del género Fusarium, que mostraron polimorfismo de acuerdo con el medio de cultivo, con crecimiento radial y anillos marcados. Se observaron microconidios y macroconidios dispersos en el micelio y en esporodoquios de color blanco, naranja y azul a 36 días. La tasa de crecimiento varió con el medio nutritivo y la cepa inoculada. Se identificaron a F. circinatum, F. lateririum, F. decemcellulare y F. mangiferae. En las pruebas de patogenicidad en laboratorio todas las cepas inoculadas fueron positivas y en campo solo F. circinatum y F. mangiferae. El bioensayo de sensibilidad mostró respuesta dependiente de fungicida y aislamiento. Con estos se concluye que las especies F. circinatum, F. mangiferae, F. lateririum y F. decemcellulare pueden causar pudrición mohosa en el panel de pica del clon IAN 710. Este es un primer reporte que involucra estas especies. Su control depende de la especie de Fusarium y el fungicida utilizado.
Palabras claves: caracterización; identificación; medios de cultivo; sensibilidad a fungicidas
Introduction
The rubber Hevea brasiliensis Muell Arg. is a perennial tropical crop well paid, of economic importance at a commercial level for its productive levels and the characteristics of its nature, raw material necessary for the industry, in the manufacture of essential items such as tires, components of engineering and latex products (Picón et al., 1997). Although it was established in plantations for more than a hundred years in Mexico and the world (Martínez, 1986), in recent years interest in natural latex plantations has resurfaced since its physicochemical characteristics cannot be obtained from synthetic rubber derived from oil (Frederico et al., 1995).
In Mexico there are 33 375 ha (INIFAP, 2014) distributed in the states of Veracruz, Oaxaca, Chiapas and Tabasco, with an estimated production of 62.4 thousand tons and a value of 685.7 million pesos (SIAP-SAGARPA, 2016). The main producing state was Veracruz, with 57.6% of the national production, followed by Oaxaca with 33%. The Tuxtepec region in Oaxaca is the most important with average production areas of 3 ha (Rojo et al., 2011) and constitutes one of the main sources of employment and income for 1 500 producers in that area.
However, despite the unbeatable conditions for commercial rubber production, the country historically maintains a deficit situation and more than 70 thousand tons per year have been imported from Thailand, Indonesia and Malaysia, equivalent to more than 90% of domestic consumption , with a cost greater than 100 million dollars a year (Rojo et al., 2011). However, the industrial importance of the plant and its product, in Mexico there is not enough information about the productive potential of the species, the management of the plantations, or the factors that influence latex production (Grist et al., 1995; Priyani, 1996).
In young plantations, there are few diseases that cause significant damage, including those caused by Botryodiplodia theobromae Pat, Phytophthora sp., Diplodia sp. or Colletotrichum sp. In mature plantations the damages are by Phytophthora palmivora Butl. Corticium salmonicolor Berk and by Ceratocystis fimbriata Elliot (Picón et al., 1997). The latter can be dispersed by the wind, the sting blade or by insects such as Xyleborus hypocryphalus (Goitia and Rosales, 2001), which decreases the yield and regeneration of its bark.
Therefore, the objective of this study was to corroborate the causative agent of the moldy rot of the sting panel in Hevea brasilensis in the common Santa Ursula, Tuxtepec, Oaxaca, as well as perform in vitro sensitivity tests with fungicides to inhibit the growth of phytopathogen.
Materials and methods
The present study was carried out in Santa Ursula, municipality of San Juan Bautista Tuxtepec, Oaxaca, which according to the Holdridge system has climatic conditions of warm subtrostingl rainforest. Average annual temperatures of 26 °C. Heavy and abundant rains, annual rainfall of 2 000 to 4 500 mm.
The samples taken were representative of the plantation. For the collection of the material, a deep cut was made in the bark of the tree with the previously sterilized sting tool, until penetrating the xylem infected by the fungus, the samples were processed in the phytopathology laboratory of the Faculty of Agrobiology ‘Presidente Juárez’ UMSNH.
Preparation of culture media
For isolation and characterization of the isolated culture media used papa-dextrose-agar (PDA), water-agar (AA), coffee-dextrose-agar (CDA), carrot-agar (ZA) and spezieller-nährstoffarmer-agar (SNA) recommended by Leslie and Summerell (2006) for the analysis and characterization of the genus Fusarium and by Beever (1969) modified by Christen and Raimbault (1991), which is a medium of liquid fermentation-agar (FLA) for Ceratocystis fimbriata ( Palma-Sandoval, 1993).
Obtaining insulations
The phytopathological techniques described by Trigiano et al. (2004); Agrios (2005), samples were seeded in ½XPDA culture medium and incubated at 28 °C in the dark, hyphae tips. For identification by fixed preparations, morphological was compared with the keys of Barnett and Hunter (1998); Leslie and Summerell (2006). Monosporic cultures were performed and stored in sterile 25% glycerol at -70 °C for use.
Cultural and morphological characterization of Fusarium isolates
Cultural characterization was performed in 1XPDA medium. 20 μL of the conidial suspension was inoculated in 25% glycerol. The characteristics of the type and thickness of the mycelium, color of the colony (front and back), agar pigmentation, presence and color of the sporodoch, presence of clamidospores were recorded, as well as the possible presence of hyphae coiled at 15, 30 and 60 days.
The morphological characterization was in CLA medium, 5 μL of the suspension was inoculated, at 10 days the length and width of 50 macroconidia and 50 microconidia of each isolation was measured, the shape, type of foot and apical cell were determined in the macroconidia, as well as the number of septa and presence of sporodochia, the shape, arrangement and type of phyloid was determined from the microconidia, along with the presence and disposition of clamidospores and rolled hyphae if possible.
Growth rate
5 μL of the suspension was inoculated in paperless SNA media, which were incubated for 7 days at 25 °C in the dark. From the colony a 6 mm diameter disc was transferred to the center of a Petri dish with ZA, FLA, CDA and PDA media with sterilized rubber stem pieces, incubated for 72 h and recorded the growth rate (mm), with the data obtained, the analysis of variance was performed with the Statgraphics Centurion XVI program (Statpoint, 2013). Five repetitions were established. The experiment was performed twice.
Pathogenicity tests
According to Dhingra and Sinclair (1985), 60 stems of Hevea brasiliensis from clone IAN-710 with 2.5 cm wide and 35 cm long were extracted from the field, disinfested with 5% sodium hypochlorite, the tips were sealed with vinyl paint and for its moved laboratory and processing were wrapped in moistened paper. Under aseptic conditions, they were washed again in 2% sodium hypochlorite. For the inoculation, 10 mm discs were placed with PDA medium with the isolate on stems with and without wound, which were covered with transparent tape. The stems were placed inside moist chambers. Five repetitions were established.
The field pathogenicity test was performed on healthy IAN-710 clone trees of 2.5 and 4.5 years of age, the concentration of conidia varied with the isolated Tux 01 (10.76), Tux 02 (3.0), Tux 03 (1.56) and Tux 04 (8.50) x106 respectively. 200 mL of each suspension was sprinkled on a wound similar to that of commercial crops, on the soft outer bark. Four repetitions were performed. The treatments were distributed in randomized blocks. The severity assessment was performed four days after inoculation with a visual scale, where: A= bark damaged; B= visible rot; C= visible mycelium; D= necrosis; and E= absence of damage.
Bioassay of in vitro sensitivity of phytopathogens to fungicides
Under the Dhingra and Sinclair (1985) technique of moistening filter paper, on Whatman No. 4 paper discs of 6 mm in diameter, the products Benomilo (2 g), Carbendazin (3 mL), Mancozed 70% (4 g), Mancozed 70% (1 kg/6 L regional control), Propiconazole (2.5 mL), Carboxamide (12 g), Chlorothalonil (12 g) and the combinations Chlorothalonil + Carboxamide (12 g), Benomyl + Mancozed 70% (2 + 4 g) recommended by AGI-Hule Papaloapan Region (2012) and distilled water (absolute control).
The discs were impregnated with 50 μL of the solution. Ten treatments were established per isolate including a regional control and an absolute. Each treatment had eight repetitions distributed completely randomly. The experimental unit was a disk. The response variable was the mycelial growth of the isolates, this was recorded after 24 h and until the mycelium of the control treatment touched the filter paper disk. The data obtained from the growth were subjected to an analysis of variance with the Statgraphics Centurion XVI statistical program (Statpoint, 2013).
Results and discussion
Of the isolates made, four isolates were obtained, which by comparison of their morphological characteristics belong to the genus Fusarium.
Cultural characteristics of Fusarium in 1X PDA culture media with rubber stem pieces, ZA, CDA and FLA
The isolates had a radial growth, with marked rings, 75% of the isolates presented abundant, cottony, loose, aerial mycelium, while the remaining 25% (Tux-01 and Tux-04 in CDA, Tux-02 in PDA and ZA) they had thin mycelium, immersed in the middle. The color of the colony was white, light yellow to brown on the obverse in all isolated and yellow, brown and black on the reverse as the colony aged, in an outstanding way, the Tux-01 isolate in PDA and CDA and Tux-04 in CDA showed a bluish coloration in the obverse. Pigmentation was observed in the culture medium in 50% of the isolates (Figure 1).
Figure 1 Cultural characterization of Fusarium isolates in culture media: PDA with rubber stem pieces, ZA, CDA and FLA.
The temperature, darkness and the culture medium are important factors for the rapid formation of pigments in this genus, which facilitates the fact of observing variability in the intensity of the coloration. In particular, the PDA medium, due to its high carbohydrate content, allows for an ideal development and expression of its cultural characteristics such as shape, color, medium pigmentation and growth range (Leslie and Summerell, 2006).
Morphological characteristics of Fusarium in PDA culture medium with rubber stem pieces
All isolates showed the formation of macroconidia, dispersed in the mycelium and in white, orange and blue sporodochs at 36 days. The predominant form was semi-straight with a dorsal curve. The number of septa varied, for Tux-01, Tux-02 and Tux-04 it was three to five, while for Tux-03 it was five to nine. The apical cell observed was papillated and hook-shaped, the basal with a light and clear notch.
The microconidia were present in the four isolates, these were hyaline, usually without septa, some with one or two. Formed in false heads, on mono and polycideids, short and long. Intercalar clamidospores and terminals present in Tux-02, Tux-03 and Tux-04 isolates. Hyphae coiled in Tux-01, Tux-03 and Tux-04.
According to Dhingra and Sinclair (1985) the PDA culture medium can stimulate the formation of clamidospores, which could facilitate their observation. On the other hand, the presence of rolled hyphae can separate Fusarium species isolated from different plant materials from pantrostingl regions that belong to the Gibberella fujikuroi complex in the Liseola section (Leslie, 1995).
Morphological characteristics of Fusarium in CLA culture medium
The macroconidia observed were dispersed in the culture medium, abundantly produced in blue and orange sporodochs for Tux-01, orange in Tux-02 and Tux-04 and white in Tux-03 that developed on carnation leaves or medium of culture after 36 days of inoculation (Figure 2A to 2D). The macroconidia were hyaline, semi-direct with a dorsal curve. In the isolated Tux-01 they presented 3 to 4 septa, the apical cell was papillated, the basal was barely notched and measured 39.06 4.4 µm.

Figure 2 Fusarium structures observed in the CLA culture medium. A and B= white and blue sporodochs on carnation leaf; C= orange sporodoquium on the medium; D= sporodoquine seen at 10X; E= macroconidio with four septa; F= macroconidio with nine septa; G= microconidia in false heads; H= intercalar clamidospores; I= terminal clamidospores; J and K= rolled hyphae.
In Tux-02 tde 3 to 5 septa, papillary apical cell, the basal with barely notch, 39.4 x 4.4 µm. Tux-03 from 5 to 9 septa, narrow apical cell and basal with clear notch, measured 57.72 x 5.8 µm and Tux-04 from 3 to 4 septa, papillary apical cell, basal with barely notched and 36.4 x 4.9 µm (Figure 2E and F).
This culture medium is excellent for the formation of Fusarium reproductive structures and their preservation, since it decreases the degeneration of the crop due to its low nutrient content (Fisher et al., 1982). The macroconidia that occur are usually uniform in size and shape, they occur between 6 and 10 days after inoculating the medium, these peculiarities provide the reason why it is the recommended culture medium for species identification work. The number of septa from 3 to 5 is frequent in species of this genus, however Tux-03 isolation with 5 to 9 (Figure 2E and 2F) coincides with those reported for the species F. decemcellulare (Ploetz et al., 1996) and F. lateritium (Leslie and Summerell, 2006).
The microconidia were formed in false heads arranged in mono or polyphilides (Figure 2G). Ovoid and without septa, the isolated Tux-01 and Tux-02 had one and two septa, while the Tux-03 and Tux-04 also had a cornered shape. The measurements were Tux-01 of 9.48 x 3.08, Tux-02 of 8.2 x 3.2, Tux-03 of 6.52 x 3.2 and Tux-04 of 7.92 x 2.8 µm. Microconidia are not produced by all species of the genus, their presence can be an important character, as well as the size, shape, the conidiogenic cells where they are born or the arrangement they have; the formation of the latter can be affected by the culture medium used.
In F. decemcellulare its shape is oval and without septa, usually formed in chains, although they can occasionally be in false heads and on monophalides, in addition to abundant in the aerial mycelium, characteristics that coincide with those observed for the isolated Tux-03 and that they are separated from F. lateririum when presented by ellipsoids with zero to three septa, individual, in monophalides and generally absent (Leslie and Summerell, 2006).
Abundant intercalar and terminal clamidospores were observed in Tux-02, Tux-03 and Tux-04 isolates. The presence of these can be a distinctive factor in some species, as well as their disposition, they are usually frequent in crops with SNA and CLA medium more than in other agar surfaces and their formation can take more than six weeks (Leslie and Summerell, 2006), its production can occur in response to changes in temperatures, it is a common survival feature in this genus (Agrios, 2005).
In three of the isolates, hyphae rolled with three and four turns were observed, preferably in aerial mycelium, with the exception of Tux-02 where they were not appreciated (Figure 2). These hyphae are similar to those formed by the species F. sterilihyphosum, F. circinatum, F. pseudocircinatum and F. mexicanum that are the only ones that produce them (Leslie and Summerell, 2006; Jacobs et al., 2007; Kvas et al., 2009; Otero-Colina et al., 2010).
Growth rate for isolates Fusarium spp.
The analysis of mycelial growth data at 72 h showed significant statistical differences between them and varied both in the isolates and in the media used. The Tukey averages comparison test α= 0.05 for each medium showed that in Tux-01 the best growth was obtained with the ZA medium (13.6 mm) in Tux-02 the ZA media (9.8 mm), CDA (9.4 mm) and PDA (8.8 mm) had a similar growth, for Tux-03 and Tux-04 the best means were ZA (9.9 and 12.6 mm) and CDA (9.9 and 11.7 mm). The lowest growth was observed in the FLA medium in all isolates(Figure 3).
The growth rate is a secondary character, the PDA medium is traditionally used and allowed to grow for three days at a temperature of 25 or 30 °C. It usually allows distinguishing fast or slow growing species (Leslie and Summerell et al., 2006).
The growth rate for F. sterilihyphosum at 25 °C is 4.8 mm day-1 (Britz et al., 1999), in F. circinatum it is relatively fast (4.7 mm day-1) at 20 °C (García, 2011), F. decemcellulare is 5-8.3 mm day-1 at 25 °C, F. mangiferae Britz, Wingfield & Marasas 3.4 mm day-1 and F. lateritium 2.6-6.6 mm day-1 (Leslie and Summmerell, 2006).
The data recorded for the Tux-01 isolates resemble those of the species F. sterilihyphosum and F. circinatum, with whom it shares the morphological characteristic of rolled hyphae. The other isolates studied are similar to those reported for F. lateritium, and F. mangiferae, since Tux-02 grew 2.9 mm day-1, Tux-03 (2.8 mm day-1) and Tux-04 (3 mm day-1); however, Tux-03 and Tux-04 have rolled hyphae and the other species do not.
When comparing the cultural, morphological characteristics and growth rate observed in the isolates studied with the descriptions made by (Klitiich y Leslie, 1992; Leslie, 1995; Huss et al., 1996, Ploetz et al., 1996; Klitiich et al., 1997; O’Donnell et al., 1998; 2000; Britz et al., 1998; 1999; Steemkamp et al., 1999a; Leslie and Summerell, 2006; Jacobs et al., 2007; Kvas et al., 2007; Kvas et al., 2009), it could be suggested that the Tux-01 isolate belongs to the species F. circinatum Nirenberg & O’Donnell emend. Britz, Coutinho, Wingfield & Marasas, the isolation Tux-02 to F. lateritium Nees, Tux-03 to F. decemcellulare Brick, and finally Tux-04 to F. mangiferae Britz, Winfield & Marasas, although it is evident and indispensable the need to confirm; through the use of molecular tools and multigenic analysis that allow to accurately distinguish each isolation.
Pathogenicity tests
In the test under controlled conditions in the laboratory, it was observed that the inoculated stems without wound did not show any signs of the disease, as did the controls, while the stems with wounds presented the characteristic symptoms within 8 to 10 days. The field pathogenicity test was positive for F. circinatum and F. mangiferae in all the trees in which they were inoculated. F. mangiferae developed a visible rot and mycelium, necrosis coinciding with the expected symptoms at 72 h, while F. circinatum did so at 92 h and in 50% of the inoculated trees. The control plants remained free of the disease despite having been injured.
The symptoms described for the disease are similar to those caused by the genus in the trunk of the Pinus halepensis pine (García, 2011), Aleppo pine (Garbelotto et al., 2007), peach (Jacobs et al., 2007), where F. circinatum by blocking the vascular bundles of plants, generates a withering of the same, with decrease in size and strength. The damage they cause is easily observed when the bark falls off, under these elongated, dark to black lesions with abundant resin there is presence of mycelium if there is high relative humidity.
The species F. lateritium and F. decemcellulare did not cause the symptoms of the disease in the field, this contradicts their results in the laboratory, the importance of environmental conditions is transcendent so that the cycle of a disease can be carried out.
Bioassay of in vitro sensitivity to fungicides
The analysis of variance indicated a different response in the presence of fungicides depending on the isolation. The fungicidal isolation interaction showed high statistical significance, as well as the Tukey mean comparison test α= 0.05 (p= 0.0001), in the effect of the treatments used on the isolates evaluated at 11 days after the bioassay was established (Figure 4).
The results of the Tukey α= 0.05 tests for F. circinatum showed that the best products for mycelial growth inhibition were Propiconazole, Mancozed (TR), Carboxamide, Chlorotlonyl + Carboxamide and Chlorothalonil. The products with the lowest inhibition were Benomyl, Carbendazin and distilled water. For the F. lateritium isolate, the best effects were presented with Propiconazole, Mancozed (TR) and Carboxamide, while Mancozed, Benomilo + Mancozed, Benomilo, Carbendazin and distilled water had the least inhibition.
For F. decemcellulare Chlorothalonil + Carboxamide and Propiconazole were the best; Benomilo and Carbendazin had a poor performance. F. mangiferae showed that the best products for inhibition were Chlorothalonil + Carboxamide, Popiconazole; Mancozed (TR) and Mancozed 70%. The rest of the products did not perform well.
The positive results observed with the use of Propiconazole for F. circinatum, F. laterirtium and F. mangiferae are similar to those reported by Serrano et al. (2014) for F. circinatum isolated from dead plants of Pinus radiata, where it was efficient. In F. decemcellulare he had a regular performance.
The Mancozed fungicide applied alone also exerted good control over the four species, a situation contrary to that referred by Mamza et al. (2010) in its evaluation on F. pallidoroseum, isolated from Ricinus communis. However, when Mancozed 70% was tested together with Benomilo, it had a low response for F. circinatum and F. decemcellulare and null for F. lateririum and F. mangiferae where he behaved as the control of distilled water.
The Benomilo applied alone, had a null functioning by not preventing the growth of the mycelium in any of the species tested, a situation close to that observed by Lara et al. (2013) for F. oxysporum of gerbera with dryer, Mendoza et al. (2011) with F. nivale and F. oxysporum in jicama Pachyrhizus erosus, Negrete et al. (2007) in Fusarium sp., isolated from Heliconia Heliconia wagneriana and Jimenez et al. (2007) with Fusarium sp., by Ginger Alpinia purpurata in both cases of radical rot.
The fungicide Carboxamide had variable results, so when it was applied it was only efficient for the species F. circinatum and F. lateritium but was regular for F. decemcellulare and F. mangiferae. When it was in combination with Chlorothalonil, its effect was good for F. circinatum, F. mangiferae and F. decemcellulare, but medium for F. laterirum, a situation contrary to that reported by Jimenez et al. (2007) where he had good control. Finally, the fungicide Carbendazin did not exert any control over the mycelium of any of the species studied, a situation that is far from that reported by Jiménez et al. (2007) and Negrete et al. (2007).
Conclusions
Four species of the genus Fusarium were isolated from the bark of the rubber sting panel with symptoms of moldy rot. This is a first report that involves this genus. According to the morphological characteristics observed, the Tux-01 isolation corresponded to the species F. circinatum Nirenberg & O’Donnell emend. Britz, Coutinho, Wingfield & Marasas. Tux-02 to F. lateritium Nees, Tux-03 to F. decemcellulare Brick and Tux-04 to F. mangiferae Britz, Winfield & Marasas.
In the growth rate, Fusarium isolates efficiently developed on culture media ZA, CDA and PDA, but not on FLA where it had a discrete growth. Laboratory pathogenicity tests were negative when no wounds were made on the stem, but positive when wounds were made. Clone IAN-710 was susceptible to the action of these phytopathogens. Field pathogenicity tests were positive for F. circinatum and F. decemcellulare.
The in vitro sensitivity study to fungicides showed great variation, the response depended on the species and fungicide. The need to confirm each described isolation through the use of molecular tools and multigen analysis is evident and indispensable.
Acknowledgments
To the Phytopathology laboratory of the Faculty of Agrobiology ‘Presidente Juárez’, of the Michoacana University of San Nicolas de Hidalgo, under the coordination of Phd. Ma. Blanca Nieves Lara Chavez who offered the necessary space to carry out this research.
REFERENCES
AGI-Hule Región Papaloapan. 2012. Identificación y control de enfermedades de tableros de pica en plantaciones de hule. Tuxtepec, Oaxaca. Folleto técnico. [ Links ]
Agrios, G. N. 2005. Plant pathology. Department of Plant Pathology University of Florida. Fifth edition. Elsevier Academic Press. USA. 922 p. [ Links ]
Barnett, H. L. and Hunter, B. B. 1998. Illustrated genera of imperfect Fungi. 4th Ed. Burgess Publishing Company Minneapolis, Minnesota USA. 218 p. [ Links ]
Beever, D. J. 1969. Nutrition of the silverleaf pathogen Stereum purpureum (Pers.) Fr. New Zealand journal of science. 12(4):268-275. [ Links ]
Britz, H.; Coutinho T. A.; Wingfield, M. J.; Marasas, W. F. O. and Gordon, T. R. 1999. Establishment of Gibberella fujikuroi mating population in H for Fusarium subglutinans f.sp. pini. Appl. Environ. Microbiol. 65(3):1198-1201. [ Links ]
Britz, H.; Wingfield, M. J.; Coutinho, T. A. and Marasas, W. F. O. 1998. Female fertility and mating type distribution in a South African population of Fusarium subglutinans f. sp. pini. Appl. Environ. Microbiol. 64(6):2094-2095. [ Links ]
Christen, P. and Raimbault, M. 1991. Optimization of culture medium for aroma production by Ceratocystis fimbriata. Biotechnology Letters. 13(7):521-526. [ Links ]
Dhingra, O. D. and Sinclair, J. B. 1985. Basic plant pathology methods. CRC Press, Inc. Boca Raton, Florida. 355 p. [ Links ]
Fisher, N. L.; Burgess, L. W.; Toussoun, T. A. and Nelson, P. E. 1982. Carnation leaves as a substrate and for preserving cultures od Fusarium species. Phytopathology. 72(1):151-153. [ Links ]
Frederico, J. C.; Aparecida, P. C. and Atamar, A. 1995. Rubber growing soils Sao Paulo, Brazil. Indian J. Natural Rubber Res. 8(2):75-84. [ Links ]
Garbelotto, M.; Schweigkofler, W. and Shaw, D. 2007. First report of Fusarium circinatum, causal agent of pitch canker disease, from the roots of mature Aleppo pines in California. Online. Plant Health Progress doi: 10.1094/PHP-2007-0219-01-BR. [ Links ]
García, S. I. 2011. Diplodia pinea (Desm.) Kickx y Fusarium circinatum Nirenberg & O”Donnell, principales hongos de chancro de las masas forestales de Pinus radiata D. Don del País Vasco. Tesis Doctoral. Universidad del País Vasco. 228 p. [ Links ]
Goitia, W. y Rosales, C. J. 2001. Relación entre la incidencia de escolitidos y la necrosis del cacao en Aragua, Venezuela. Manejo Integrado de Plagas. 62(4):65-71. [ Links ]
Grist, P.; Ken, M. and Lo, T. 1995. Modelling rubber growth as a function of climate and soils. Indonesian Rubber Research Institute: Imperata Project Paper 1995/6. 67 p. [ Links ]
Huss, M. J.; Campbell, C. L.; Jennings, D. B. and Leslie, J. F. 1996. Isozyme variation among biological species in the Gibberella fujikuroi species complex (Fusarium section Liseola). Appl. Environ. Microbiol. 62(10):3750-3756. [ Links ]
INIFAP. 2014. Potencial productivo de especies agrícolas de importancia socioeconómica en México. Primera edición. ISBN 978-607-425-766-3. 140 p. [ Links ]
Jacobs, A.; Coutinho, T. A.; Wingfield, M. J.; Ahumada, R. and Wingfield, B. D. 2007. Characterization of the pitch canker fungus, Fusarium circinatum, from Chile. South Afr. J. Sci. 103. [ Links ]
Jiménez, C. M.; Ávila, T. C.; Pedraza, M. E. y Rodríguez, A. G. 2007. Etiología de la pudrición radical de ginger Alpinia purpurata K. Schum y su control químico in vitro. In: Memoria de la quincuagésima tercera reunión anual de la sociedad interamericana para la horticultura tropical realizada en Morelia Michoacán, México. [ Links ]
Klittich, C. J. R. and Leslie, J. F. 1992. Identification of a second mating population within the Fusarium moniliforme anamoprh of Gibberella fujikuroi. Mycologia. 84(4):541-547. [ Links ]
Klittich, C. J. R.; Leslie, J. F.; Nelson, P. E. and Marasas, W. F. O. 1997. Fusarium thapsinum (Gibberella thapsina): a new species in section Liseola from Sorghum. Mycologia. 89(4):643-652. [ Links ]
Kvas, M.; Steenkamp, E. T.; Al Adawi, A. O.; Deadman, M. L.; Jahwari, A. A.; Marasas, W. F. O.; Wingfield, B. D.; Ploetz, R. C. and Winfield, M. J. 2007. Fusarium mangiferae associated with mango malformation in the Sultanate of Oman. Eur. J. Plant Pathol. 121:195-199. Doi 10.1007/s10658-007-9231-8. [ Links ]
Kvas, M.; Marasas, W. F. O.; Wingfield, B. D.; Wingfied, M. J. and Steenkamp, E. T. 2009. Diversity and evolution of Fusarium species in the Gibberella fujikuroi complex. Fungal Diversity. 34(1):1-21. [ Links ]
Lara-Chávez, M. B. N.; Belmonte-Ruíz, D. C.; Salgado-Salgado, R.; Ávila-Val, T. C.; Vargas-Sandoval, M.; Aguirre-Paleo, S.; García-Gutiérrez, A.; Olalde-Lira, G. G. y Guillén-Andrade, H. 2013. Etiología de la secadera en Gerbera sp. y su sensibilidad in vitro a fungicidas. In: Memoria del décimo quinto Congreso Nacional y primer Internacional de SOMECH, celebrado en Puebla, Puebla, México. [ Links ]
Leslie, J. F. 1995. Gibberella fujikuroi: available populations and variable traits. Can. J. Bot. 73(Suppl. 1):S282-S291. [ Links ]
Leslie, J. F. and Summerell, B. A. 2006. The Fusarium laboratory manual. Blackwell Publishing. Iowa, USA. 387 p. [ Links ]
Mamza, W. S.; Zarafi, A. B. and Alabi, O. 2010. In vitro evaluation of six fungicides on radial mycelial growth and regrowth of Fusarium pallidoroseum isolated from castor (Ricinus communis) in Samaru, Nigeria. Archiv. Phytopathol. Plant Protec. 43(2):116-122. [ Links ]
Martínez, C. F. 1986. Las lecciones de historia. In: el hule en México. Ediciones Copilco, SA. México. 102-113 pp. [ Links ]
Mendoza, G. Z. Y.; Rodríguez, G. G. A.; Ávila, V. T. C.; Ochoa, A. S. y Lara, Ch. M. B. N. 2011. Bioensayo de control in vitro de patógenos fungosos de la jícama (Pachyrhizus erosus). In: Memoria del décimo sexto Congreso Nacional de Ciencias Hortícolas, realizado en Culiacán, Sinaloa, México. 226 p. [ Links ]
Negrete, G. R.; Pedraza, M. E.; Fernández, S.; Ávila, T. C. y Negrete N. 2007. Etiología y control químico in vitro de la pudrición radical en Heliconia wagneriana Petersen. In: Memoria de la quincuagésima tercera reunión anual de la sociedad interamericana de la horticultura tropical, realizada en Morelia, Michoacán, México. 190 p. [ Links ]
O’Donnell, K.; Cigelnik, E. and Nirenberg, H. I. 1998. Molecular systematic and phylogeography of the Gibberella fujikuroi species complex. Mycologia. 90(3):465-493. [ Links ]
O’Donnell, K.; Nirenberg, H. I.; Aoki, T. and Cigelnik, E. 2000. A multigene phylogeny of the Gibberella fujikuroi species complex: detection of additional phylogenetically distinct species. Mycoscience. 41(1):61-78. [ Links ]
Otero-Colina, G.; Rodríguez-Alvarado, G.; Fernández-Pavía, S.; Maymon, M.; Ploetz, R. C.; Aoki, T.; O’Donnell, K. and Freeman, S. 2010. Identification and characterization of a novel etiological agent of mango malformation disease in México, Fusarium mexicanum sp. nov. Phytopathology. 100(11):1176-1184. [ Links ]
Palma-Sandoval, 1993. Reportes de biotecnología. Contribución al estudio del crecimiento del hongo Ceratocystis fimbriata en medio de cultivo líquido y sólido para la producción de metabolitos volátiles. UAM. ORSTOM. 48 p. [ Links ]
Picón, R.; Cervantes, O. L. E. y Hernández, C. J. M. 1997. Manual para el cultivo el hule Hevea brasiliensis Muell Arg. Instituto Nacional de Investigaciones Forestales, Agrícolas y Pecuarias (INIFAP)-Centro de Investigación Regional Golfo Centro-Campo Experimental El Palmar. Tezonapa, Ver. Folleto técnico núm. 18. 103 p. [ Links ]
Ploetz, R. C.; Vazquez, A. and Benscher, D. 1996. First report of Fusarium decemcellulare as a pathogen of mango in the United States. Plant Disease. 80(10):1207. [ Links ]
Priyani, S. 1996. The growth, phase change and rejuvenation of trees with special reference to Hevea brasiliensis Müll. Arg. Journal of the Rubber Res. Institute of Malaysia. 78:1-14. [ Links ]
Rojo, M. G.; Martínez, R. R. y Jasso, M. J. 2011. El cultivo del hule en México. Universidad Autónoma Indígena de México y Colegio de Postgraduados, Campus Montecillo, Estado de México. Libros Técnicos. Serie Forestal. 317 p. [ Links ]
Serrano, Y.; Elvira‐Recuenco, M.; Conde, M.; Troya, M. T. and Raposo, R. 2014. In vitro evaluation of wood preservatives to prevent dispersal of pitch canker pathogen, Fusarium circinatum. J. Phytopathol. 163(9):783-786. [ Links ]
SIAP-SAGARPA. 2016. Cierre de la producción agrícola por cultivo. Anuario estadístico de la producción agrícola. Consultado 17- 08-16 en Consultado 17- 08-16 en http://www.siap.sagarpa.gob.mx/ . [ Links ]
Statpoint, V16.2.04. 2013. Statgraphics centurion XVI.I, statistical analysis system. Copyright 2009 by StatPoint Technologies, Inc. All rights reserved. V16:2:04. [ Links ]
Steenkamp, E. T.; Wingfield, B. D.; Coutinho, T. A.; Wingfield, M. J. and Marasas, W. F. O. 1999a. Differentitation of Fusarium subglutinans f. sp. pini. By histone gene sequence data. Appl. Environ. Microbiol. 65(8):3401-3406. [ Links ]
Trigiano, N. R.; Windham, T. M. and Windham, S. A. 2004. Plant pathology, concepts and laboratory excercises. CRC Press. 413 p. [ Links ]
Received: July 01, 2019; Accepted: September 01, 2019











 text in
text in 




